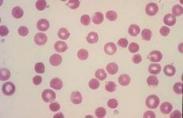

江門福康門診地址
628健康網(m.xgzic.com)為您匯集最新關于江門福康門診地址的健康知識大全、江門福康門診地址最新消息資訊等有關江門福康門診地址的文章知識介紹,供您參考。
江門福康門診地址
-
江門福康門診
628健康網醫院大全頻道為您提供江門福康門診簡介,江門福康門診介紹,江門福康門診怎么樣,江門福康門診好不好,江門福康門...
-
閻乙夫
閻乙夫,男,主治醫師,2011年畢業于北京大學醫學部,博士學位。專于泌尿外科常見疾病的診治,于中國微創外科雜志、臨...
-
閆新宇
閆新宇,男,副主任醫師,碩士,從事耳鼻咽喉科臨床、教學和科研工作。14年扎實的臨床工作和北京中醫醫院良好的中醫氛...
-
附紅細胞體病
628健康網為您分享有關附紅細胞體病的癥狀,附紅細胞體病的治療方法,附紅細胞體病的預防知識,附紅細胞體病的癥狀圖片,附...
-
孫麗蘊
孫麗蘊,女,首都醫科大學附屬北京中醫醫院,皮膚科,主任醫師,醫學博士,首都醫科大學及北京中醫藥大學碩士研究生導...